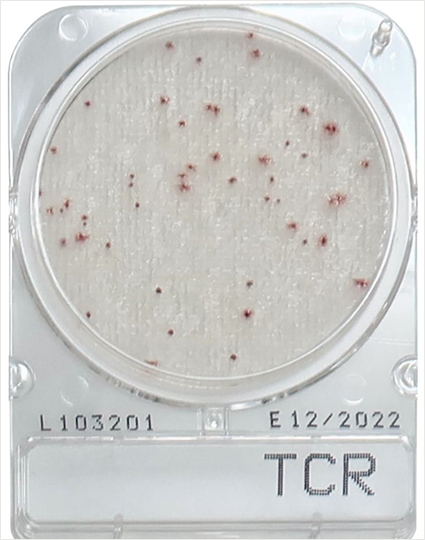
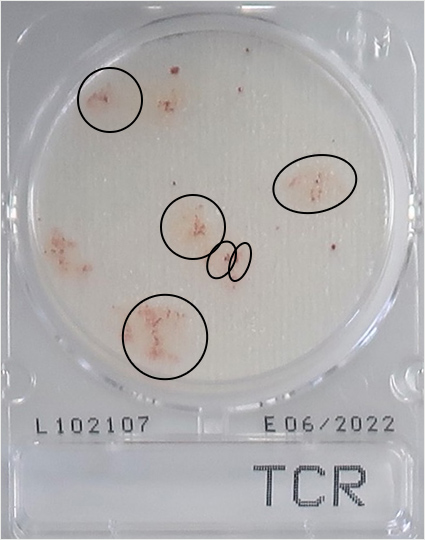
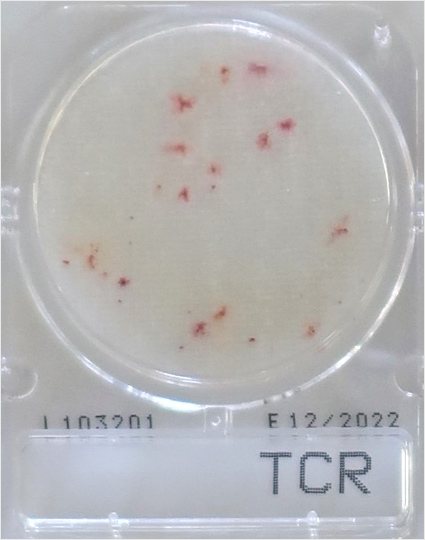
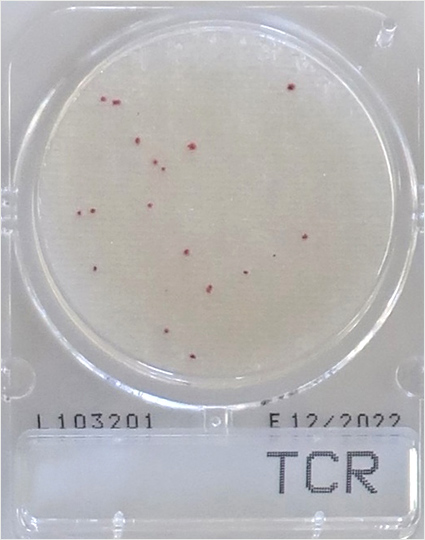
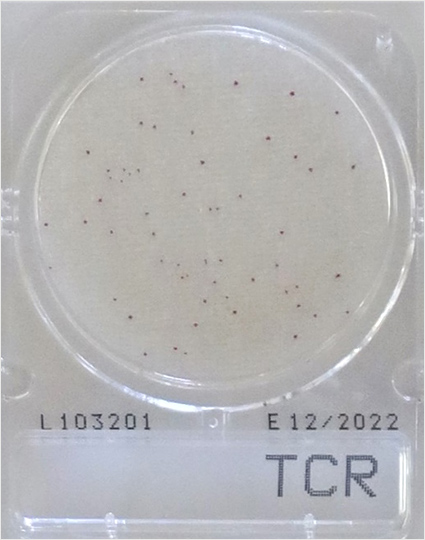
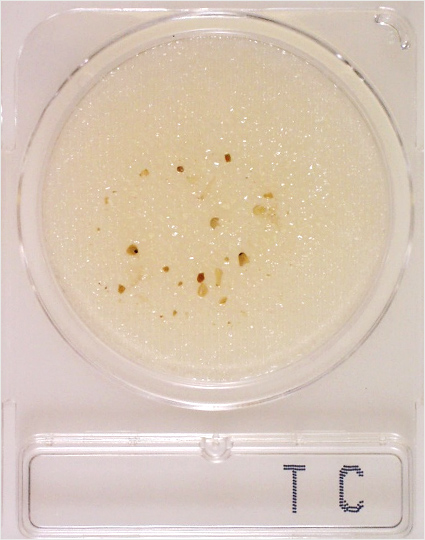
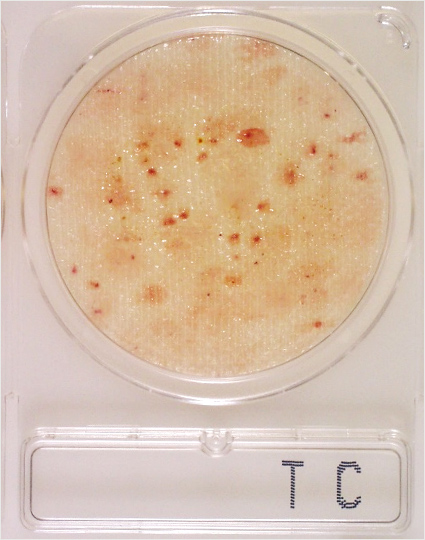

コンパクトドライ™ 判定ガイドコンパクトドライ™ TCR
本ガイドは、コンパクトドライ™ TCRの培養結果について適切に理解していただくためのものです。その他の製品については以下をご参照ください。
コンパクトドライ™ TCR
| 用途 | 一般生菌数測定用(迅速タイプ) |
|---|---|
| TCR | TC, Rapid |
| 認証 | AOAC-PTM認証 |
| 特長 | ・一般生菌数の発育を24時間で迅速測定可能 ・標準寒天培地を用いた従来の培養法と高い相関性 ・コロニーが発色するので、測定が簡単 |
| 判定方法 | 培養温度 35±1℃(乳製品を除く全食品) 35±1℃ or 32±1℃(乳製品) 判定時間 24±2時間(迅速測定) 48±3時間(従来法に合わせた測定) 赤色コロニーを形成 |
拡散したコロニーのカウント
※判定方法は、コンパクトドライ TCと基本的に同じです。

A 赤い発色が薄いコロニーもカウントしてください。
A 赤い芯の回り発色が広がっていますが、これも1つのコロニーとして数え、赤丸内の合計コロニー数は、青丸で囲んだ3個とカウントします。

A 高い運動性を持つ菌の場合、プレート上に広がった状態のコロニーを形成する場合があります。広がったコロニーは単独のコロニーと判定します。
ポイント
コンパクトドライに検体試料液を接種すると、試料液はシート全体に均一に広がります。ゆえに検体中に存在した細菌も均一に広がっていて、発育したコロニーは均一に存在するはずです。一部分に菌が密集して発育することはないと考え、シート全体を見て判定してください。
広がりやすい菌が多いとわかっている検体は、段階希釈を多くするなどの工夫をするとよいでしょう。
シート全体が赤い・適切な希釈段階
牛ひき肉検体を10倍から104倍に段階希釈した試料液を接種して培養しました。
104倍希釈で43個とカウントできます。希釈倍率から推測すると、10倍希釈は約43,000個、102倍希釈は約4,300個、103倍希釈が約430個となります。
コンパクトドライでは1プレートに1,000個を超えるとカウントしにくくなります。10,000個を越えるとコロニー化せずにシート全体が赤く着色したようになります。300個以下のコロニー数となるように試料を適切に希釈してください。




ポイント
菌が多すぎて着色しているが赤みが弱い、あるいは、運動性が非常に高い菌がシート全体に拡散して菌が生えているのか迷うとき、フタを少し開けて臭いをかいでみてください。菌が発育している場合は、特有の臭いがありますので、これらの情報もあわせて観察してください。
いろいろな検体のコロニー形状
食品検体によって、そこに含まれる菌叢も様々で、それぞれの特有の形状のコロニーが現れます。

※以下の画像はコンパクトドライ TCの事例ですが、コンパクトドライ TCRでも同様です
食品残渣物が入るとコロニーと間違えやすいので注意します。食品残渣物とコロニーとの見分けも大切です。フィルター付きバックを使用することをお勧めします。
カレールウのような濃い色がついた食品検体は、食品検体の色が邪魔をしてコロニーが見えなくなります。しかし、カレールウの場合は、もう一段階希釈すればカウント可能となります。
加熱した食品では広がったコロニー(耐熱の芽胞菌)が認められることが多いようです。

ポイント
検体からの影響を受ける場合は、希釈し、影響を緩和してください。